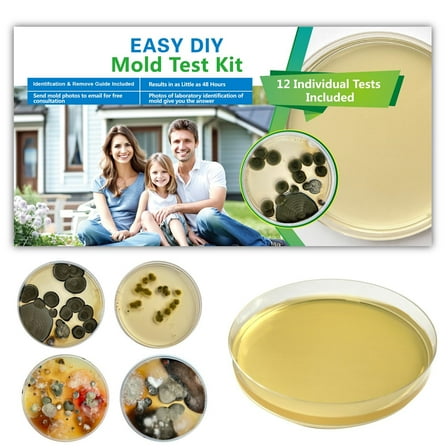
Mold Test Kit for Home - 12 Simple Detection Tests,Test HVAC System,Home Surfaces,& Indoor Air Quality Testing Kits,DIY Mold Detector at Home,Includes Detailed Mold Identification Guide,air Tester

Sorry, this item is out of stock
Mold Test Company DIY Mold Air Detection Test Kit $19.95
 $1995current price $19.95
$1995current price $19.95Mold Test Company DIY Mold Air Detection Test Kit
223.8 out of 5 Stars. 22 reviewsPRO-LAB Mold Detection Test Kit for Air and Surfaces $12.89
 $1289current price $12.89
$1289current price $12.89PRO-LAB Mold Detection Test Kit for Air and Surfaces
1774 out of 5 Stars. 177 reviewsMold test kit for home 10 pics $28.88
 $2888current price $28.88
$2888current price $28.88Mold test kit for home 10 pics
Best seller MOLD ARMOR Do-It-Yourself Mold Detection Test Kit $11.97
 $1197current price $11.97
$1197current price $11.97MOLD ARMOR Do-It-Yourself Mold Detection Test Kit
1444.3 out of 5 Stars. 144 reviewsMold Test Kit for Home Detection: 8 Simple DIY Science Kits for Fastly Testing Home Surfaces & Air Quality Detector & HVAC Monitor Includes Detailed Identification Guide $16.99
 More options from$1599
More options from$1599Mold Test Kit for Home Detection: 8 Simple DIY Science Kits for Fastly Testing Home Surfaces & Air Quality Detector & HVAC Monitor Includes Detailed Identification Guide
15 out of 5 Stars. 1 reviewsImmunolytics DIY Mold Test Kit - Easy to Use Professional 5 Plate Room Screening Kit $39.00
 $3900current price $39.00
$3900current price $39.00Immunolytics DIY Mold Test Kit - Easy to Use Professional 5 Plate Room Screening Kit
294.1 out of 5 Stars. 29 reviewsMold Test Kit for Home Within 2 Individual Tests,Test HVAC,Home Surfaces,Indoor Air Quality Testing Kits,Skin Test,DIY Black Mold Detector Testing kit,Mold Identification Guide-Free Lab Analysis $16.13
 $1613current price $16.13
$1613current price $16.13Mold Test Kit for Home Within 2 Individual Tests,Test HVAC,Home Surfaces,Indoor Air Quality Testing Kits,Skin Test,DIY Black Mold Detector Testing kit,Mold Identification Guide-Free Lab Analysis
44 out of 5 Stars. 4 reviewsAir Mold Test Kit - Evviva Sciences - 5 Simple Mold Detection Tests - Optional Lab Analysis - Test HVAC System, Room Air, & Home Surfaces - Includes Detailed Mold ID Guide $24.99
 $2499current price $24.99
$2499current price $24.99Air Mold Test Kit - Evviva Sciences - 5 Simple Mold Detection Tests - Optional Lab Analysis - Test HVAC System, Room Air, & Home Surfaces - Includes Detailed Mold ID Guide
174.4 out of 5 Stars. 17 reviewsImmunolytics Easy to Use Professional DIY Mold Test Kit for Home - Individual Room Screening Package $43.00
 $4300current price $43.00
$4300current price $43.00Immunolytics Easy to Use Professional DIY Mold Test Kit for Home - Individual Room Screening Package
15 out of 5 Stars. 1 reviewsPRO-LAB DIY Mold Test Kit - LAB FEE Included (3 Test Methods: Air, Surface, Bulk.) $49.97
 $4997current price $49.97
$4997current price $49.97PRO-LAB DIY Mold Test Kit - LAB FEE Included (3 Test Methods: Air, Surface, Bulk.)
65 out of 5 Stars. 6 reviewsMold Testing Kit with 5 Individual Tests - DIY Mold Test Kit for Home - Includes Detailed Mold Identification Guide - Fast and Reliable Mold Detector for Home$$ $71.23
 $7123current price $71.23
$7123current price $71.23Mold Testing Kit with 5 Individual Tests - DIY Mold Test Kit for Home - Includes Detailed Mold Identification Guide - Fast and Reliable Mold Detector for Home$$
Evviva Sciences Mold Test Kit for Home - 10 Easy DetectionTests w/Optional Lab Analysis (Extra Fee), Test HVAC System, Surfaces, & Indoor Air Quality Testing Kit - Downloadable Mold Information Guide $59.83
 $5983current price $59.83
$5983current price $59.83Evviva Sciences Mold Test Kit for Home - 10 Easy DetectionTests w/Optional Lab Analysis (Extra Fee), Test HVAC System, Surfaces, & Indoor Air Quality Testing Kit - Downloadable Mold Information Guide
Mold Test Kit for Home - 12 Simple Detection Tests,Test HVAC System,Home Surfaces,& Indoor Air Quality Testing Kits,DIY Mold Detector at Home,Includes Detailed Mold Identification Guide,air Tester $38.15
$3815current price $38.15
$3815current price $38.15Mold Test Kit for Home - 12 Simple Detection Tests,Test HVAC System,Home Surfaces,& Indoor Air Quality Testing Kits,DIY Mold Detector at Home,Includes Detailed Mold Identification Guide,air Tester
Mold Test Kit 1 PK (5 Bus. Days) Schneider Labs $37.50
 $3750current price $37.50
$3750current price $37.50Mold Test Kit 1 PK (5 Bus. Days) Schneider Labs


First Alert MT1 Take Home Mold Detection Test Kit
Key item features
- Comprehensive Testing: This kit tests for and identifies various types of molds present in either home or workplace environments.
- Complete Contents: The kit includes all necessary components for a mail-in mold test, such as six test tapes, three polybags, a test card, a manual, and a preprinted return envelope.
- Mail-In Analysis: Designed for convenient mail-in submission, allowing users to send samples for professional laboratory analysis.
- Detailed Identification: Lab analysis, available for an additional fee per sample, provides specific identification of the type of mold growth detected.
- Premium Detection: The product is categorized as a premium mold detection kit, indicating its specialized function in identifying mold.
Specs
- BrandFirst Alert
- Rec. useMold Testing Kits
- Pack quantity1
- SizeEA
How do you want your item?
About this item
Product details
- TEST KITS
- MOLD DETECTION
- PREMIUM
Specifications
Brand
Rec. use
Pack quantity
Size
Warranty
Warranty information
Please be aware that the warranty terms on items offered for sale by third party Marketplace sellers may differ from those displayed in this section (if any). To confirm warranty terms on an item offered for sale by a third party Marketplace seller, please use the 'Contact seller' feature on the third party Marketplace seller's information page and request the item's warranty terms prior to purchase.
Warnings
Popular items in this category
Best selling items that customers love
SpeedySwab™ At-Home Covid-19 and Flu A/B Test Kit, Results in 15 Minutes, 1 Test $10.45 Was $15.98 29.9 ¢/g
 SponsoredNow$1045current price Now $10.45, Was $15.98$15.9829.9 ¢/g
SponsoredNow$1045current price Now $10.45, Was $15.98$15.9829.9 ¢/gSpeedySwab™ At-Home Covid-19 and Flu A/B Test Kit, Results in 15 Minutes, 1 Test
Save withShipping, arrives in 2 daysPRO-LAB RA100 Radon Gas Do It Yourself Test Kit $9.88 Was $12.79
 SponsoredNow$988current price Now $9.88, Was $12.79$12.79
SponsoredNow$988current price Now $9.88, Was $12.79$12.79PRO-LAB RA100 Radon Gas Do It Yourself Test Kit
1194.3 out of 5 Stars. 119 reviewsShipping, arrives in 3+ daysHealthful Home Whole Home Mold Inspection Pack - Tests 3 Separate Areas $89.98
 $8998current price $89.98
$8998current price $89.98Healthful Home Whole Home Mold Inspection Pack - Tests 3 Separate Areas
15 out of 5 Stars. 1 reviewsSave withShipping, arrives in 2 daysImmunoLytics DIY Mold Test Kit - Easy to Use Precise 3 Swab Kit $118.00
 $11800current price $118.00
$11800current price $118.00ImmunoLytics DIY Mold Test Kit - Easy to Use Precise 3 Swab Kit
Shipping, arrives in 3+ daysEvviva Sciences Mold Detection Test Kit with 10 Individual Tests, 10 Piece $45.55
 $4555current price $45.55
$4555current price $45.55Evviva Sciences Mold Detection Test Kit with 10 Individual Tests, 10 Piece
163.8 out of 5 Stars. 16 reviewsShipping, arrives in 3+ daysPRO-LAB Asbestos Test Kit $12.59
 $1259current price $12.59
$1259current price $12.59PRO-LAB Asbestos Test Kit
774.3 out of 5 Stars. 77 reviewsShipping, arrives in 3+ daysWELLlife COVID-19/FLU A&B Home Test, FDA EUA Authorized -[25 Tests] $149.98
![WELLlife COVID-19/FLU A&B Home Test, FDA EUA Authorized -[25 Tests]](https://i5.walmartimages.com/asr/137c9964-340c-4c6d-a150-0293dc27f25b.1edd55b4673ce230579bd3f8f82d71ed.jpeg?odnHeight=576&odnWidth=576&odnBg=FFFFFF) $14998current price $149.98
$14998current price $149.98WELLlife COVID-19/FLU A&B Home Test, FDA EUA Authorized -[25 Tests]
Shipping, arrives in 3+ daysWELLlife Flu A&B Home Test, Flu Test 1 Test the First FDA Authorized Influenza Rapid Test Kit for Home Use Result in 10 Minutes $5.99 Was $8.99
 Now$599current price Now $5.99, Was $8.99$8.99
Now$599current price Now $5.99, Was $8.99$8.99WELLlife Flu A&B Home Test, Flu Test 1 Test the First FDA Authorized Influenza Rapid Test Kit for Home Use Result in 10 Minutes
55 out of 5 Stars. 5 reviewsSave withShipping, arrives in 2 daysAdvin Respiratory Test Kit 66-9990-3, 2 Ct $10.99
 2 optionsAvailable in additional 2 options$1099current price $10.99Options from $10.99 – $26.79
2 optionsAvailable in additional 2 options$1099current price $10.99Options from $10.99 – $26.79Advin Respiratory Test Kit 66-9990-3, 2 Ct
113.8 out of 5 Stars. 11 reviewsSave withShipping, arrives in 2 daysClearance 240ml Home Wall Mold & Mildew Remover, White Wall Safe Cleaner—Spray & Wipe Stain Removal, Prevents Mold Growth, Christmas Holiday Home Deep Cleaning Essential $7.27 Was $11.27
Clearance Now$727current price Now $7.27, Was $11.27$11.27+$3.99 shipping
Now$727current price Now $7.27, Was $11.27$11.27+$3.99 shipping240ml Home Wall Mold & Mildew Remover, White Wall Safe Cleaner—Spray & Wipe Stain Removal, Prevents Mold Growth, Christmas Holiday Home Deep Cleaning Essential
Shipping, arrives in 3+ daysGenaCheck COVID-19 / Flu A+B, At-Home Respiratory Test Kit (4 Tests) | OTC Nasal Swab | Ages 2+ | Easy to Use Self-Test | Fast Results - 1 Kit, 4 Tests per Kit $30.69
 3 optionsAvailable in additional 3 options$3069current price $30.69Options from $30.69 – $162.00
3 optionsAvailable in additional 3 options$3069current price $30.69Options from $30.69 – $162.00GenaCheck COVID-19 / Flu A+B, At-Home Respiratory Test Kit (4 Tests) | OTC Nasal Swab | Ages 2+ | Easy to Use Self-Test | Fast Results - 1 Kit, 4 Tests per Kit
Shipping, arrives in 3+ daysBest seller 2 in 1 Moisture Meter, for Mold Self-Testing,Water Leak Detector,Moisture Sensor for Firewood,Drywall Mold Detector $21.25
Best seller $2125current price $21.25
$2125current price $21.252 in 1 Moisture Meter, for Mold Self-Testing,Water Leak Detector,Moisture Sensor for Firewood,Drywall Mold Detector
214.2 out of 5 Stars. 21 reviewsShipping, arrives in 3+ daysRollback BinaxNOW™ COVID-19/Flu A&B Combo Self-Test with Fast, Reliable Results in 15 Minutes, 4 Count Pack $34.88 Was $39.88
Rollback Now$3488current price Now $34.88, Was $39.88$39.88
Now$3488current price Now $34.88, Was $39.88$39.88BinaxNOW™ COVID-19/Flu A&B Combo Self-Test with Fast, Reliable Results in 15 Minutes, 4 Count Pack
2734.2 out of 5 Stars. 273 reviewsSave withPickup todayDelivery todayShipping, arrives tomorrowWELLlife COVID-19 Rapid Antigen Home Test Kit, 2 Tests per Kitbox with Holder $5.99 Was $7.91
 Now$599current price Now $5.99, Was $7.91$7.91
Now$599current price Now $5.99, Was $7.91$7.91WELLlife COVID-19 Rapid Antigen Home Test Kit, 2 Tests per Kitbox with Holder
634.9 out of 5 Stars. 63 reviewsSave withShipping, arrives in 2 daysMoldex 7010 Mold & Mildew Instant Stain Remover Trigger Sprayer, 32 oz - Pack of 3 $35.11
 $3511current price $35.11
$3511current price $35.11Moldex 7010 Mold & Mildew Instant Stain Remover Trigger Sprayer, 32 oz - Pack of 3
Shipping, arrives in 3+ daysWELLlife™ COVID-19/Influenza A&B (FLU A&B) Home Testing kit - [1 Tests] $15.99
![WELLlife™ COVID-19/Influenza A&B (FLU A&B) Home Testing kit - [1 Tests]](https://i5.walmartimages.com/seo/WELLlife-COVID-19-Influenza-A-B-FLU-A-B-Home-Testing-kit-1-Tests_549c22e6-6c63-4442-871c-9959b40f2c78.82fad843c2854f428fde8db3b407bad2.jpeg?odnHeight=576&odnWidth=576&odnBg=FFFFFF) 2 optionsAvailable in additional 2 options$1599current price $15.99More options from $6.79
2 optionsAvailable in additional 2 options$1599current price $15.99More options from $6.79WELLlife™ COVID-19/Influenza A&B (FLU A&B) Home Testing kit - [1 Tests]
1294.5 out of 5 Stars. 129 reviewsSave withShipping, arrives in 2 daysWELLlife COVID-19/Influenza A&B Home Test, Self Test for Flu A/B and COVID-19, Results in 10 Minutes with Non-invasive Nasal Swab, FDA EUA Authorized -[5 Tests] $29.99
![WELLlife COVID-19/Influenza A&B Home Test, Self Test for Flu A/B and COVID-19, Results in 10 Minutes with Non-invasive Nasal Swab, FDA EUA Authorized -[5 Tests]](https://i5.walmartimages.com/asr/cdefb976-19af-4ed9-aeb4-04653a13e6b9.3893caa172fc7ae8cfee43e40f339472.jpeg?odnHeight=576&odnWidth=576&odnBg=FFFFFF) $2999current price $29.99
$2999current price $29.99WELLlife COVID-19/Influenza A&B Home Test, Self Test for Flu A/B and COVID-19, Results in 10 Minutes with Non-invasive Nasal Swab, FDA EUA Authorized -[5 Tests]
324.7 out of 5 Stars. 32 reviewsSave withShipping, arrives in 2 days
Check out these related products
PRO-LAB RL116 Long-Term Radon Gas Test Kit $12.97 Was $29.99
 SponsoredNow$1297current price Now $12.97, Was $29.99$29.99
SponsoredNow$1297current price Now $12.97, Was $29.99$29.99PRO-LAB RL116 Long-Term Radon Gas Test Kit
204.1 out of 5 Stars. 20 reviewsShipping, arrives in 3+ daysFirst Alert RD1 Fast Results Radon Gas Test Kit $24.04
 $2404current price $24.04
$2404current price $24.04First Alert RD1 Fast Results Radon Gas Test Kit
254.2 out of 5 Stars. 25 reviewsShipping, arrives in 3+ daysProfessional Lab RA100 Do It Yourself Radon Test Kit - Quantity of 3 $59.89
 $5989current price $59.89
$5989current price $59.89Professional Lab RA100 Do It Yourself Radon Test Kit - Quantity of 3
Shipping, arrives in 3+ daysCoghlan's Drinking Water Germicidal Tablets - 50 Tablets, For Emergency, First-Aid or Survival Kit Use $13.17
 2 optionsAvailable in additional 2 options$1317current price $13.17
2 optionsAvailable in additional 2 options$1317current price $13.17Coghlan's Drinking Water Germicidal Tablets - 50 Tablets, For Emergency, First-Aid or Survival Kit Use
364.4 out of 5 Stars. 36 reviewsShipping, arrives in 3+ daysRX Pill Disposal XL, Safe Effective Solution, Destroy and Deactivate Prescription Medication Drug Medicines, XLarge 64oz Capacity $169.00
 $16900current price $169.00
$16900current price $169.00RX Pill Disposal XL, Safe Effective Solution, Destroy and Deactivate Prescription Medication Drug Medicines, XLarge 64oz Capacity
Shipping, arrives in 3+ daysAirborne 1000mg Vitamin C Immune Support Multivitamin Effervescent Tablets, Elderberry Flavor, 20 ct $20.40 0.0 ¢/count
 $2040current price $20.400.0 ¢/count
$2040current price $20.400.0 ¢/countAirborne 1000mg Vitamin C Immune Support Multivitamin Effervescent Tablets, Elderberry Flavor, 20 ct
1964.6 out of 5 Stars. 196 reviewsShipping, arrives in 3+ days
Customer ratings & reviews
Filtered and sorted results would be available on the new 'Customer ratings & reviews' page.
Showing 1-3 of 21 reviews
Verified Purchase
Great value and easy to do
I was very pleased with this product and how easy it was to use and how quickly I got the lab results back!
Great product along with awesome customer service.
This product is awesome and cheap. I am renting an apartment and I found what I thought was mold. After waiting a month for management to take care of the problem I purchased this kit. The lab fee is $10 per sample. That is cheap. As it turns out I have very high levels of aspergillus and black mold on my wall and in the HVAC system. Now I have proof of what is making me sick. The customer service is unbeatable. It is done thru Moldlab in Carrollton, Texas. I will use this product again where ever I move to.
Great product! Lower cost than most!
First of all, I think the bad reviews on this are from people that do not know what mold testing usually costs. If you hire someone to inspect for mold and test it, it costs $300-$400 at the least. Other do-it-yourself mold kits cost more to buy then cost close to double of what this cost per each sample sent to the lab. I have no idea how anyone thought they would pay $12 for the kit and the lab would test the mold for free. The $10-$12 per sample is well worth it. We got quick and professional results within a little over a week. Toxic Black mold was found in our home and we have since moved. We are now going to sue the landlord of the last place die to his failure to maintain, which caused the mold to start growing. I think this is a great product.
